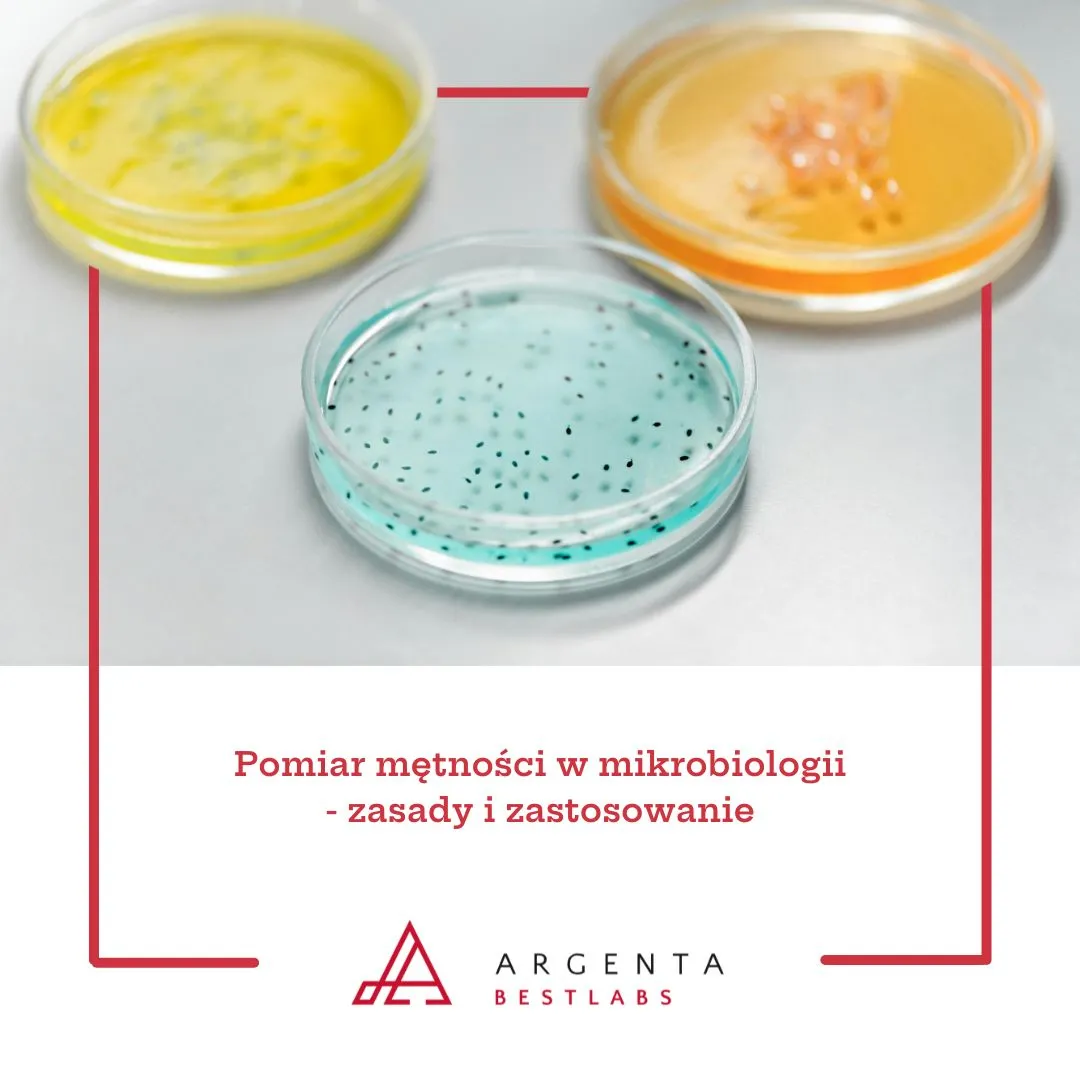
Pomiar mętności w mikrobiologii - zasady i zastosowanie

Pomiar mętności, określany również jako pomiar zmętnienia, jest jedną z podstawowych metod oceny zagęszczenia zawiesin mikroorganizmów. W laboratoriach mikrobiologicznych parametr ten pełni kluczową rolę w standaryzacji próbek, umożliwiając przygotowanie zawiesin o powtarzalnym stężeniu komórek bakteryjnych. Dzięki temu możliwe jest prowadzenie badań porównywalnych, zgodnych z wymaganiami norm i procedur branżowych.
Na czym polega pomiar mętności?
Mętność cieczy to zmniejszenie jej przejrzystości na skutek obecności zawieszonych cząsteczek - w przypadku mikrobiologii są to przede wszystkim komórki drobnoustrojów. Pomiar mętności pozwala w sposób pośredni oszacować liczbę mikroorganizmów w próbce. W praktyce badawczej stosuje się zarówno metody wizualne, jak i instrumentalne, w zależności od potrzeb laboratorium i rodzaju prowadzonej analizy.
Metody pomiaru mętności i zmętnienia
Do wykorzystywanych metod należą:
- Metody wizualne - porównanie zawiesiny z roztworami wzorcowymi. W tej grupie znajdują się wzorce McFarlanda (McFarland standards), stosowane do standaryzacji zawiesin bakteryjnych.
- Metody instrumentalne - oznaczenia wykonywane przy pomocy turbidymetrów lub nefelometrów, które mierzą rozpraszanie światła przez zawieszone w cieczy komórki.
Oba podejścia są zgodne z wymaganiami mikrobiologii praktycznej. Metody wizualne cechują się prostotą, natomiast pomiary instrumentalne zapewniają wysoką powtarzalność i dokładność.
McFarland standard i McFarland standards
Powszechnie stosowanym narzędziem do pomiaru zmętnienia są wzorce McFarlanda. Każdy McFarland standard odpowiada określonemu zagęszczeniu mikroorganizmów w zawiesinie.
Stosowanie McFarland standards umożliwia laboratoriom porównywanie próbek w sposób zgodny z procedurami referencyjnymi. Dzięki ujednoliceniu wartości możliwe jest wykonywanie testów zgodnych z wytycznymi międzynarodowych organizacji, takich jak ISO, EUCAST czy CLSI.
Zastosowania pomiaru mętności w laboratoriach
Pomiar mętności i pomiar zmętnienia są wykorzystywane w wielu obszarach mikrobiologii, m.in.:
- w testach wrażliwości bakterii na antybiotyki,
- w przygotowywaniu próbek o znormalizowanej liczbie komórek,
- w ocenie jakości próbek wody i żywności,
- w monitorowaniu dynamiki wzrostu mikroorganizmów w hodowlach płynnych,
- w badaniach środowiskowych i diagnostycznych.
Normy i standaryzacja pomiaru
Pomiar mętności jest ściśle powiązany z wymaganiami systemów jakości oraz norm międzynarodowych. Przykładowo:
- ISO 20776 - dotycząca badań nad wrażliwością bakterii na środki przeciwdrobnoustrojowe,
- EUCAST - europejskie wytyczne w zakresie standaryzacji testów wrażliwości,
- CLSI - amerykańskie standardy procedur mikrobiologicznych.
Wszystkie te dokumenty wymagają stosowania ujednoliconych metod przygotowania zawiesin, a wzorce McFarlanda pełnią w tym procesie rolę narzędzia referencyjnego.
Podsumowanie
Pomiar mętności i pomiar zmętnienia to kluczowe procedury w pracy laboratoriów mikrobiologicznych. Umożliwiają one przygotowanie zawiesin o powtarzalnym stężeniu, co jest niezbędne do prowadzenia analiz zgodnych z międzynarodowymi normami. McFarland standard i McFarland standards są powszechnie stosowanymi rozwiązaniami, które wspierają standaryzację badań i zapewniają porównywalność wyników.
Sprawdź produkty do pomiaru mętności na Bestlabs
Niektóre z produktów dostępnych w tej kategorii to wyroby medyczne przeznaczone wyłącznie do użytku profesjonalnego, zgodnie z art. 2 pkt 1.26 Ustawy o wyrobach medycznych. Produkty te nie są przeznaczone do stosowania w warunkach domowych. Szczegółowe informacje o przeznaczeniu, zastosowaniu oraz zasadach zakupu znajdują się na stronie produktu w sklepie bestlabs.pl.